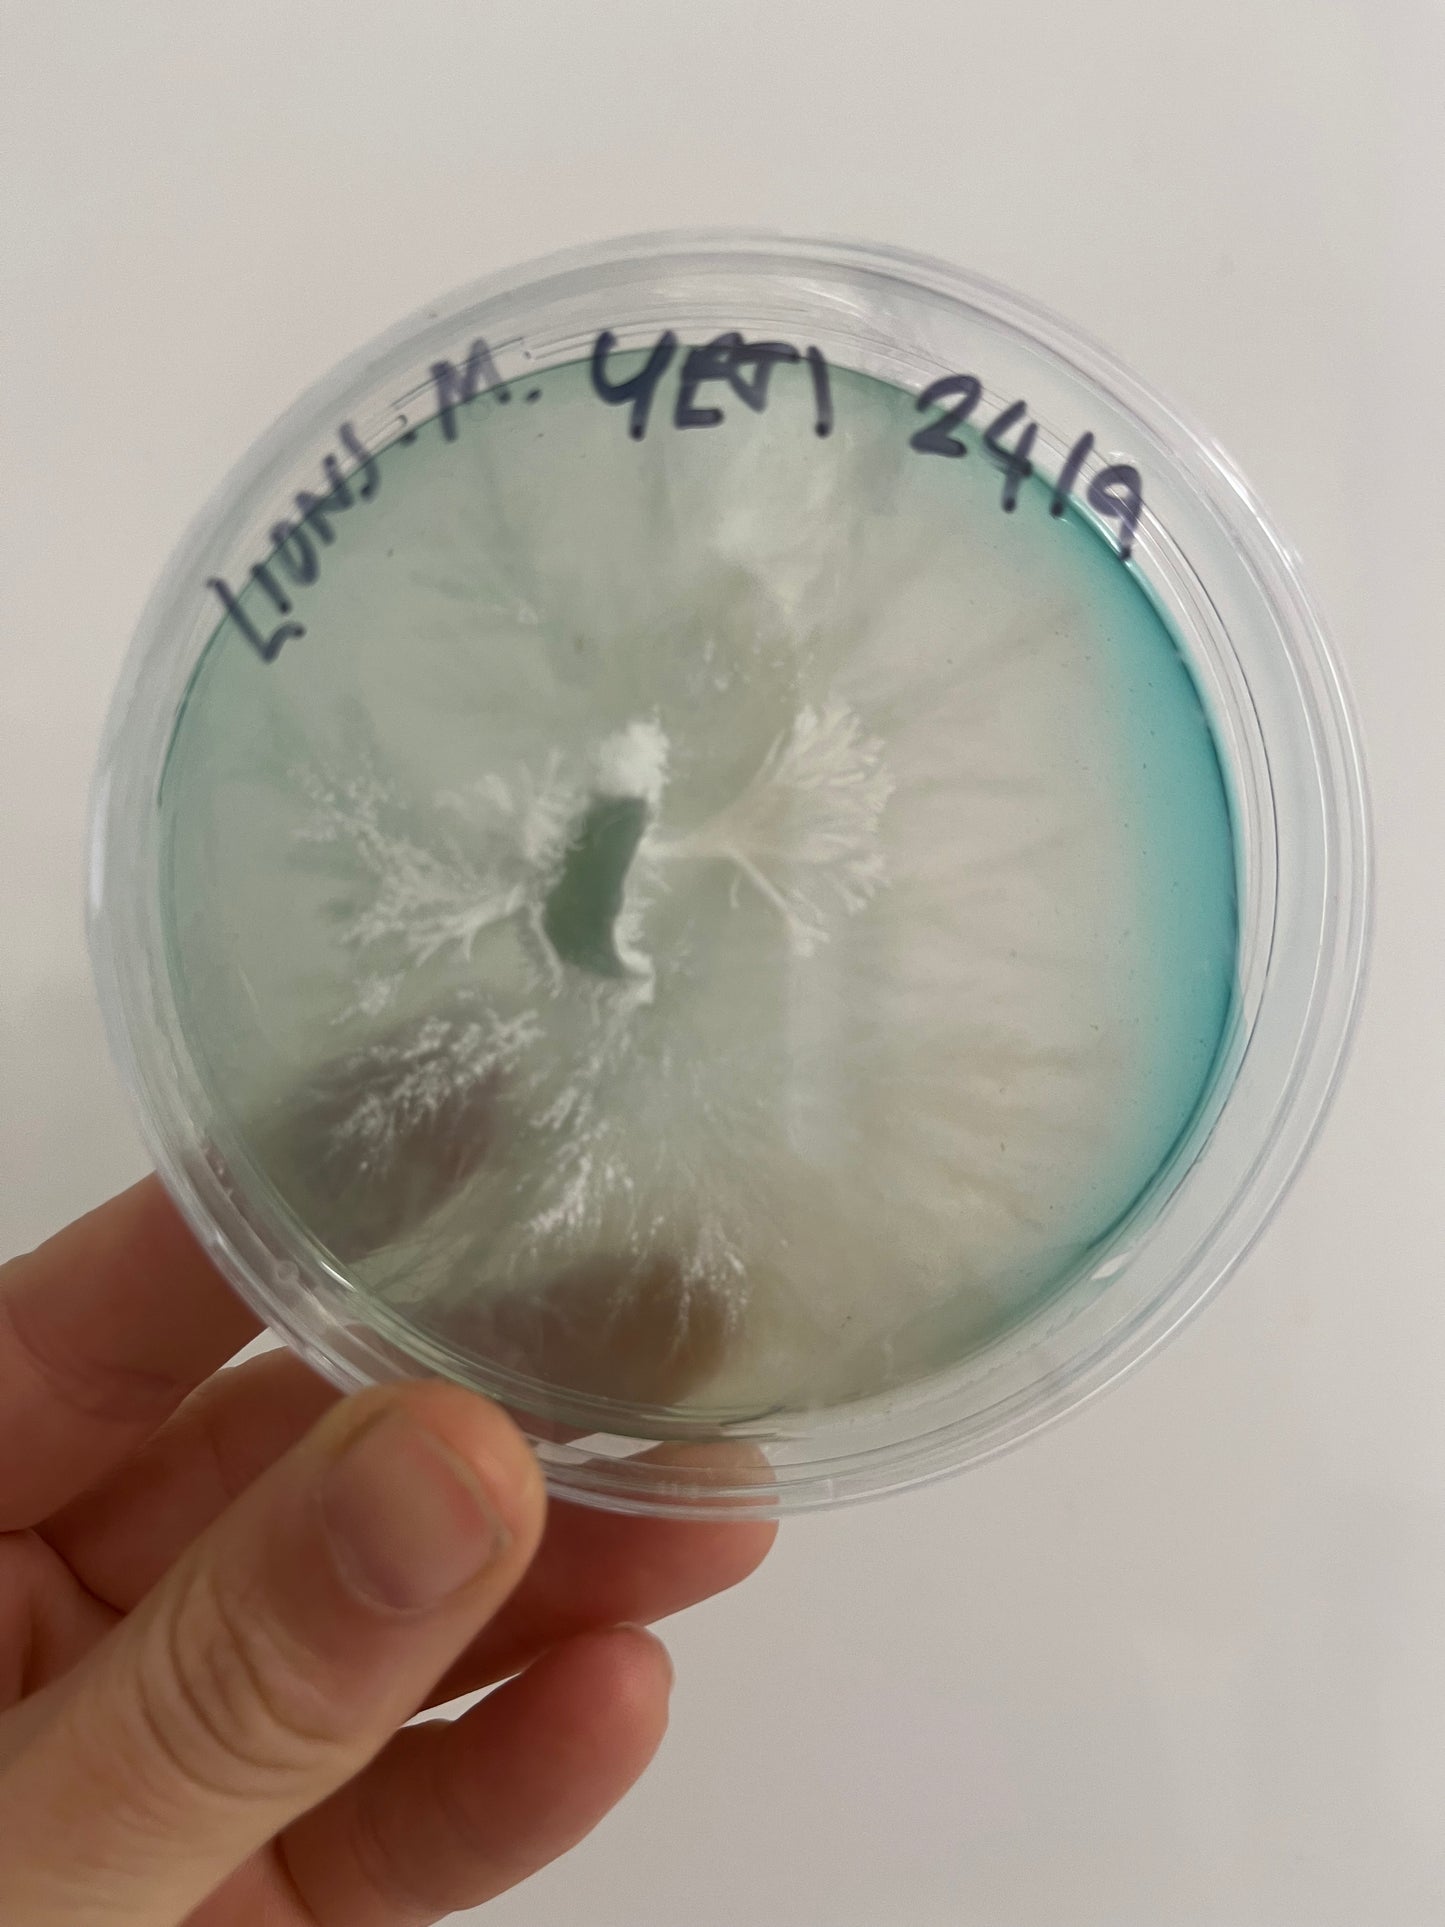
Mycology at Home - 21st January - Stockport - 6:30pm

stockportfungi
Mycology at Home - 21st January - Stockport - 6:30pm
Mycology at Home - 21st January - Stockport - 6:30pm
Couldn't load pickup availability
In this session, you’ll learn how to safely and confidently work with mushroom cultures at home. We’ll cover:
-
Building a Still Air Box for clean work
-
Cloning mushrooms onto agar plates
-
Preparing and inoculating grain for spawn
-
Tips for avoiding contamination and keeping your cultures healthy.
All materials are provided, and you’ll get to try hands-on techniques that allow you to grow mushrooms from tissue and liquid mycelium at home...giving you a long-term supply of your own mushrooms. No experience needed, maybe perfect for people who want to take their mushroom growing further.
By the end of the session, you’ll leave with your own agar plates and grain jars, plus the knowledge to keep your mycology lab going at home.
21st January, SK1 3AY 6:30pm
Sessions last approx 1.5hrs
Please note we cannot refund any cancelations within 72 before the event.
Share